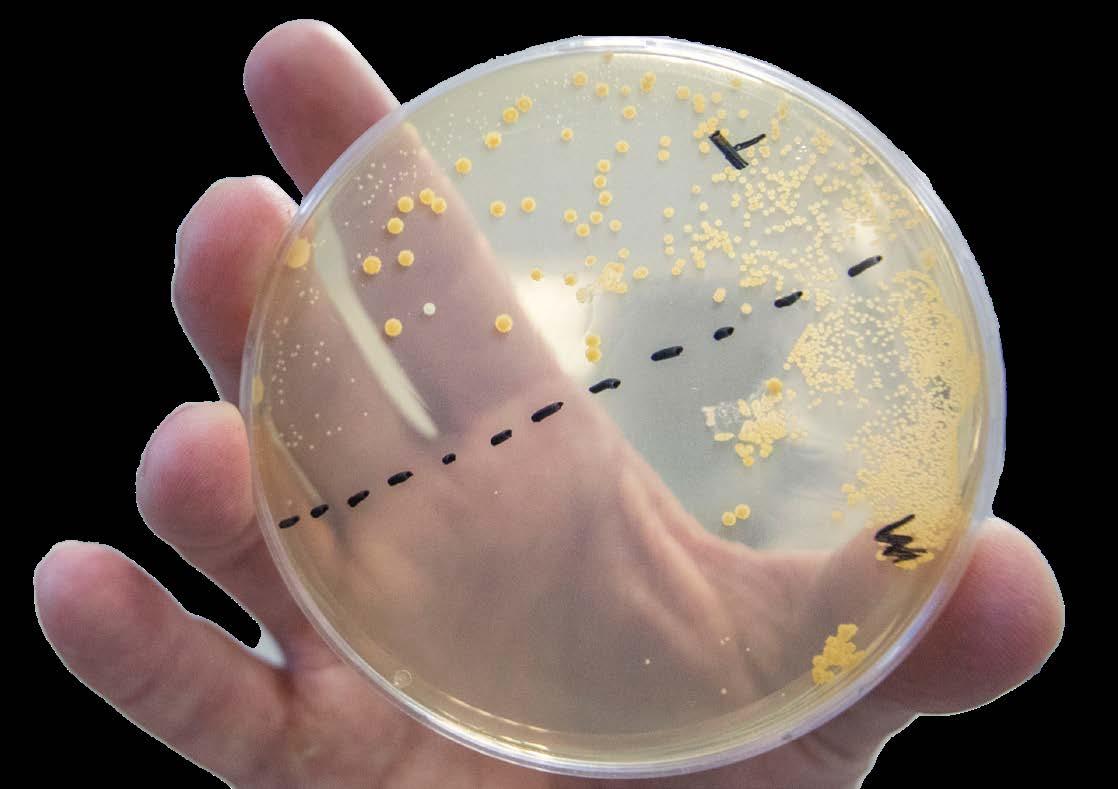
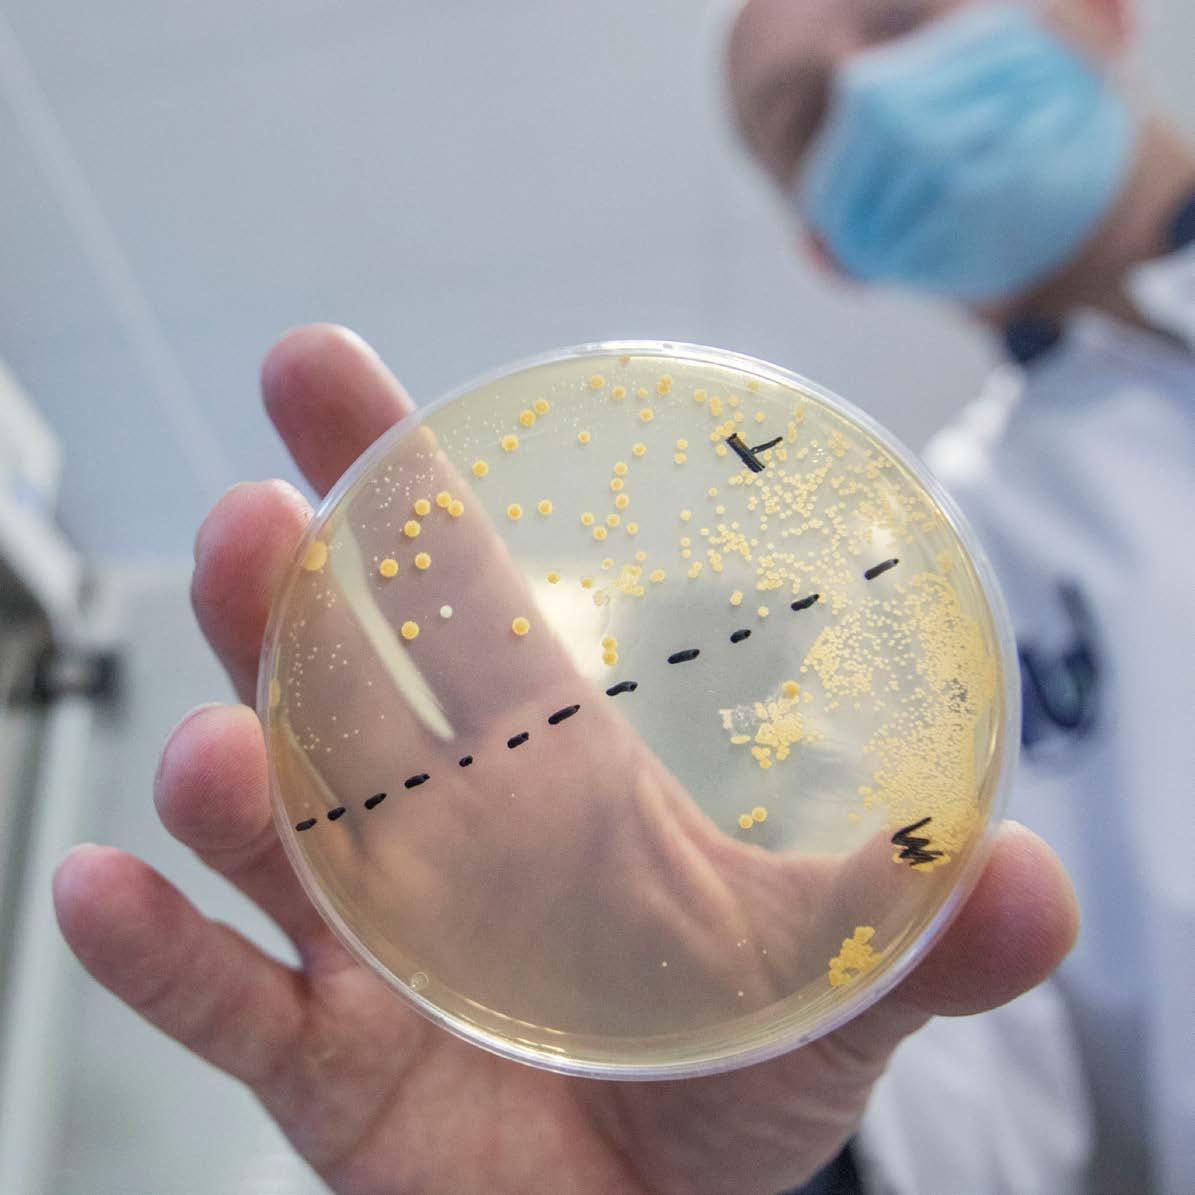

What a joy it was finally returning to campus! 2022 was the year in which we were able to meet up again in lecture rooms, laboratories, offices and at coffee machines.
For me personally, it made all the difference. I started in the tail of the pandamic and I have no idea how I could have got to know the Faculty if the pandamic were still raging. After almost two years of severe restrictions, I think we all realise that there is nothing that beats meeting people face to face, no matter whether we're teaching, doing research or involved in administration.
It is all about people, and seeing pepole on a computer screen simply is less fun and less inspiring than meeting them in person. In this year's Our Talents and Discoveries you can read about what drives our people and how that leads to exciting achievements.
Enjoy the bright views of Leiden Science!
Jasper Knoester Dean, Faculty of Science


New board members bring a breath of fresh air, and this year Leiden Science has had a real influx of new board members, including three scientific directors. Ignas Snellen is the new director of the Leiden Observatory, Marcellus Ubbink of the Leiden Institute of Chemistry and Martina Vijver of the Institute of Environmental Sciences. Who are they and what do they stand for?
What do you hope to have achieved once your term of office has come to an end?
Ignas: ‘I hope that the Leiden Observatory will be an institute where everyone enjoys working, and that people all over the world think: Leiden, that’s where I want to work.’
Martina: ‘At the Institute of Environmental Sciences (CML), we want to make the world a better place. My focus will be on creating a good workplace for young people so that they can make a difference in the world.’
Marcellus: ‘That we are still excellent in chemical science. We’re already extremely good at what we do, but we could make that better known in the outside world. That calls for a safe workplace where diverse kinds of people – different ages, nationalities and genders – can work and flourish.’
A safe workplace. How are you going to make sure of that?

Ignas: ‘This is an issue that needs constant attention. How can we make sure that if things go wrong, they’re picked up quickly? We’re currently discussing this at length with all our colleagues.’
Martina: ‘At our institute we’re trying to create a “flat” organisation. We’ve divided our research into programmes based on sustainability goals, and we’re making young people the drivers of these programmes.’
Marcellus: ‘A sense of social safety has to be on every agenda, so that it becomes a standard part of our conversation.
We’re working on our strategy for the coming years and this issue is very important. It’s also good that as institutes we learn from one another. We ought to be looking to one another a lot more often for inspiration.’
What has been the best science news this year?
Martina: ‘Ignas winning the Spinoza Prize! And, of course, that everyone is engaging more with sustainability and that we can support that with our research.’
Ignas: ‘Yes, that Spinoza is great, but for our institute the James Webb Space Telescope is the high point of the year. A lot of people from Leiden are involved in it. It’s really fantastic.’
Marcellus: ‘The Nobel Prize for Chemistry. One of the three winners gave a talk here a week before the presentation. A lot of our people are working actively in that field: chemical biology. That really gives you an energy boost.’
If you weren’t a scientist, what would you be doing?
Ignas: ‘Footballer or drummer. Both of these appeal to me, but I didn't get beyond amateur level.’
Marcellus: ‘As a child, I wanted to be a wildlife photographer. I often went out into nature with my grandfather.
But it wasn’t really my thing to spend the whole day lying in a field with my camera. I’m too impatient for that.’
Martina: ‘Radio diagnostics technician, although I didn’t actually know that word at the time. If you broke a bone, you’d have an X-ray. I thought that was really cool; I wanted to make those photos.’
Is there life outside work? What do you do in your free time?
Martina: ‘I have an enormous St. Bernard dog! Not to mention children and a partner. I play tennis too, although I never seem to get any better at it.’
Marcellus: ‘I do macro photography. Nature again.’
Ignas: ‘Every Saturday I go to football with my son. I’ve done it for years, so maybe there is still that bit of hope…’
Student counsellor Romke Biagioni is committed to helping students get through their studies and student life. She supports students who have disabilities, looks for solutions to practical problems and advises students with social, personal or financial problems.
Biagioni has been at the University since 1997. ‘And I still find it fascinating and very enjoyable,’ she says with a big smile. ‘I deal with all the problems students face. These are not only study-related, but also problems in their personal life. I’m a bit of a link between the world of therapy and the University.’
She specialises mainly in psychological problems, such as AD(H)D, anxiety and autism, but also dyslexia and physical disabilities. ‘The problems these students face are different from other students. Together, we look for ways for them to

gain and maintain control of their own life.’
She always works with the students so they can find solutions together. ‘I like it when people are different. It’s interesting to see what we can achieve together.’
Support to grow Biagioni has been a big support for MSc student of Computer Science Ruduan Plug, who has autism spectrum disorder, during his studies. ‘I could always go to Romke with my problems. Every time, she helped me in a personal and profound way.’
Partly thanks to Biagioni, Ruduan feels that he has grown tremendously in recent years. ‘She and her colleagues gave me the support that allowed me to develop and get to know more people. Their help has given me a lot more opportunities.’
During her masters’s thesis in Astronomy, Nashanty Brunken worked in a team with only women. These female astronomers discovered the largest molecule ever to have been identified so far in a planet-forming disc. ‘I have learned so much, and because we are all women it’s incredibly empowering. It’s very cool to see how far we have come with this team.’
Even as a teenager, Nashanty dreamt of becoming an astronomer. So, when she was eighteen, she moved from Curaçao to Leiden. ‘I chose Leiden because it has one of the best astronomy programmes in Europe,’ Nashanty says. When telling people about her dream, she was often asked whether astronomy isn’t a male-dominated study. ‘But during my first year I saw that the male to female ratio is about 50-50.’

She chose a subject in astrochemistry for her master’s thesis. ‘Because I really liked the course on this subject during my master’s. I also loved the experimental project in astrochemistry that I took part in during my bachelor’s.’
During the research, the team discovered the largest molecule ever identified in a planet-forming disc.
This discovery led to an academic article and a press release. ‘It feels really special to have the research for my master’s thesis published in a scientific journal. But I didn't do it alone: it was a big team effort. And it's really nice to realise that we are all women and that we achieved this together. It shows that we women can do anything.’
Facility building manager Ankie Schoonheim is positivity itself. She loves her work and starts every morning with a big smile. ‘Some people look forward to their retirement, but I’m happy that I still have fifteen years to go. My team feels like family!’

No day is the same for Ankie. ‘Every morning at seven, I cycle around the buildings to check if there is anything unusual. Afterwards we have a team meeting to see what has to be done that day. I would almost say this is my favourite time of the day, but actually I enjoy every moment of the day.’
As Facility Building Manager, she ensures that everything in the buildings works and is in perfect order.
‘Staff come with questions about internal moves, broken locks and just about everything else around the building. I love solving small technical issues.’
Ankie is also present at all the faculty events. ‘We make sure beforehand that everything is ready to receive visitors. On the day itself, it brings me so much joy to see everything going well and that everyone is happy. When I hear at the end of the day that we did well, I couldn't be prouder of our team.’
The working environment is Ankie’s biggest motivation. ‘What I love the most about work is the people I work with. We can rely on each other, and there’s a real sense of togetherness. I like working with different types of people: from cleaning staff to management. I see my work as chocolate: it makes me immensely happy.’

Aske Plaat is the Scientific Director of LIACS, the Leiden Institute of Advanced Computer Systems. He is also an ambassador for Leiden University’s LGBT+ Network. His enthusiasm shines through when he explains why.


‘Diversity? For me, that starts with Alan Turing. Turing is the founder of Computer Science, and that’s what our institute is all about. Turing was a scientist and also a war hero. In World War II, he worked at Bletchley Park, the British codebreaking centre and, together with other mathematicians, cracked the Germans' encryption system. But Turing was also a homosexual, which at the time was illegal. He was prosecuted and convicted, and eventually committed suicide, deeply unhappy because it was impossible for him to be the person he was.’
Freedom to be who you are ‘Leiden University has the ideal motto: Praesidium libertatis, bastion of freedom. It means freedom to be who you are and to love who you want to love. And it stands for freedom of
thought, because science can only exist in freedom. Science works better when you are comfortable in your own skin, when you can be yourself. And it works better when you are in it together, as part of a diverse group of scientists. That's my personal experience: to be truly successful in science, you need to work together with more people from different backgrounds. And that certainly includes LGBT+ people.’
Be kind to each other ‘I don't like pigeonholing people; everyone should simply be able to be themselves. I want us to be kind to each other in this organisation. It is totally okay to be gay, or nonbinary or whatever. After all, the very first person in our
‘

Astronomer Ignas Snellen was out walking his dogs when the Dutch Research Council (NWO) phoned to tell him he had won the Spinoza Prize. ‘I was flabbergasted.’ The prize of 2.5 million euros will enable him and his team to continue their research on exoplanets: planets orbiting other stars than our sun.
For Snellen, the award of the Spinoza Prize came just in time. ‘My ERC Advanced Grant ends this year in November. This new prize will mean I can continue my research without having to jump through hoops applying for new grants.’
Gaining this extra time is very welcome because, on 16 August, Snellen also became Scientific Director at the Leiden Observatory.
What research brought you this prize?
‘My team and I have developed a method to use ground telescopes to study exoplanets. They’re less costly and better at detecting weak signals than space telescopes. However, they first have to look through our own Earth’s atmosphere. That atmosphere disturbs signals from space. We’ve developed a calibration technique that filters out this effect and allows us to pick up a clear signal from the exoplanet.’
‘It’s impossible to observe most exoplanets directly since they are extremely far away and don’t emit light themselves. That’s why we use indirect observations, based on observations of the star that the exoplanets orbit around. When an exoplanet passes in front of this star, the light temporarily shines through the exoplanet’s atmosphere, resulting in a brief change in light intensity and composition. By measuring this change, we can tell more about the planet’s characteristics, such as the chemical compositionof its atmosphere, or its rotational speed.’
What results has this ‘Leiden’ method yielded?
‘We were the first to detect carbon monoxide and arguably water vapour in the atmosphere of exoplanets. Besides that, we were also able to determine the rotation and weather patterns such as winds for a number of exoplanets. The planets we looked at are relatively close to the Earth, by the way; planets further away are still too difficult.’
Is there anything left to dream about after winning a Spinoza Prize?
‘In about five years’ time the ELT, the Extremely Large Telescope, will be ready in Chile. That means a giant leap forward that will enable us to detect water vapour and other gases in more places. This telescope will eventually be upgraded with even better instruments. Then we expect to be able to make spectacularly better observations. There’s a planet revolving around our neighbour Proxima Centaurus that is in such an orbit that the climate may be similar to that on Earth. It’ll be really exciting to see what we find there.’
Could that be extraterrestrial life?
‘Who knows, but if there is life there, I’m thinking mainly of bacterial life rather than all the kinds of lifeforms that we know on Earth. Once these second-generation instruments are operational, in 2035 or maybe a bit sooner, we’ll be able to inspect a handful of planets that are close to their sun. I’m 52 now and I hope to detect oxygen on an exoplanet in my time as a researcher. Or at least to witness other researchers finding it.’
Ignas Snellen (52) has been Professor of Observational astrophysics at the Leiden Observatory since 2012. He has also recently become Scientific Director of the institute. Snellen has many firsts to his name, including the first measurement of the length of a day on an exoplanet. He was also the first to detect carbon monoxide in an exoplanet atmosphere. In 2016, Snellen received an ERC Advanced Grant. He was elected member of the KNAW in 2021 and was awarded the Spinoza Prize in June 2022.

Amidst the lathes and workbenches at the Fine Mechanical Department (FMD), you can find Emiel Wiegers. He and his colleagues design and construct components for researchers' set-ups. ‘We are a bunch of inventors who enjoy helping the researchers in our Faculty.’

Scientific research often requires very technical constructs that have never been made before. ‘Think of a holder for a probe microscope or a heating element, or a vacuum-drawn experimental chamber. Name any physical object that doesn’t exist yet, and we can make it for you.’
You name it, we make it Every member of the Faculty can come to the department for technical advice. ‘Mostly they are PhD students who need help with a new research set-up. Then we sit down together to see what functionalities the construction parts need. Should the
A hobby at a high-tech level
First, a 3D drawing is designed and then they can really get down to work. ‘That's the best part: simply creating new objects out of a chunk of material. And making the people you build it for happy.’ The smallest requests can be completed in half an hour, but some projects take up to three years to design, build and finetune.
Wiegers always enjoys seeking new solutions to technical problems. ‘We are a team of inventors with an interest in technology. For the past nineteen years, I have always loved coming to work. I used to do model building as a hobby and this


Who do you call when you are stuck writing a paper? This year, ten writing coaches have started at our Faculty. Their mission: helping students complete their writing assignments. Claudia Santos Gonçalves and Jetse van Os are among the coaches. What drives them to help others write better?

‘I really enjoy writing,’ Claudia kicks off. ‘I enjoy exploring languages. I think that’s my favourite part about writing: always trying to improve my text, always looking for new words to convey its meaning better.’ Jetse: ‘During the writing coach training, I read this quote: ‘‘Writing is not a box that you just throw information in. It is a tool to communicate the information you want to share.’’ That really sparked something within me.’
Jesse: ‘Just start writing. You can’t improve on something you haven’t written yet.’ Claudia: ‘Know the story that you want to tell so you don’t get lost in all the information around it.’
This project goes beyond giving writing assistance. ‘We’re mostly reassuring students that are going through this writing process,’ Claudia explains, ‘because it can be quite daunting for them.’ Jetse continues: ‘A lot of people coming from high school don’t know what they are getting into; they feel thrown in at the deep end. So, I think it’s great that we as writing coaches can guide them. We can show them what it’s really like to write for


of the Year 2021. During a lunch with fellow nominees, student assessor Joost Barendse presented him with a cheque to spend on educational activities.

‘I’m speechless,’ said Schrama on receiving the award. ‘Here I am, sitting among the Faculty's best lecturers: winning is an enormous honour.’ As well as being amazed, Schrama was also delighted, because, as he said, he’s not the kind of person who wins prizes. ‘The last time I was four years old, and I won a colouring competition at the local bakery. But this is something completely different!’

and offering hands-on education, such as when he organised a scavenger hunt at the beginning of the corona pandemic. It was so successful that it was held again this year, without the corona measures.
‘Maarten really understood the negative impact of the pandemic and online education on students,’ according to the jury report. It also states that Schrama always aims to make his lectures as interactive as possible. ‘He tries to stimulate students to think for themselves and to ask questions, instead of just studying for an exam. He wants them to see the bigger picture.’
Life Science and Technology student Rose Vossen was lured to the atrium of the Gorlaeus Building under the pretext of a study association board meeting. But instead of a meeting, a surprise ceremony with cake and champagne awaited her: Vossen had won the Young Star Award for the best bachelor’s student of 2021.

The Industrial Microbiology lab in Delft did not have a plan laid out for Vossen’s bachelor’s project, so she brainstormed with her supervisors to find a suitable project. ‘It was a bit stressful at first, but it turned out great. I loved the freedom I was given,’ she says. Vossen modified,
grew and studied different yeast strains to see whether they can be used to produce proteins for meat substitutes. A perfect fit: ‘I want to eat vegetarian, but just love meat; that’s why I’m interested in developing sustainable substitutes.’
Juggling with Erlenmeyer flasks
Creating, growing and testing in just three months is quite a challenge. ‘It would usually take longer,’ says Vossen. ‘Everyone advised me not to grow and test all of them, but I really wanted to try. With luck, and careful planning, it worked.’ Rose was quite relaxed. ‘It was mainly a logistical challenge. At some point, I found myself running around with sixteen Erlenmeyer flasks, trying to get everything done at the same time.’
One of the highest marks ever Vossen’s hard work paid off. Professor Robert Mans from Delft University of Technology praised Vossen for her boundless dedication. ‘After consulting with my colleague Rinke van Tatenhove-Pel, we decided that we would take on the adventure and act as Rose’s direct supervisors.’ They had no cause to regret their decision, as was clear from the final grade: a 9.5 out of 10: one of the highest marks given for a BSc final project in the past fifteen years.


A student assessor has the chance to take a look behind the scenes of the Faculty. That is exactly what Ava Bauer loves about her job. ‘It’s a privilege to see the effort and energy people put into making the University tick.’
‘It may sound unoriginal,’ she begins, ‘but my job is all about making the right connections.’ As student assessor, Ava is part of the Faculty Board and her role is to represent student interests in policy decisions. ‘I need to have a broad enough perspective to give useful input to decisions that ultimately affect all other students as well. That’s why I need to speak to just the right people within our organisation to effectively convey the needs and wants of our students. It’s challenging, but also a lot of fun.’
Ava joined the board at just the right time, because next year is a big one. ‘We will be bringing out the new strategic plan,’ Ava explains, ‘in which we lay out the future path of the Faculty of Science. That means almost everything is on the agenda right now. That includes the things I’m most interested in, like student wellbeing, diversity and digitalisation. It’s an amazing year to be in this position!’
Student wellbeing and diversity are crucial to Ava. ‘Fortunately, important steps were already taken on these issues last year,’ she says. ‘So, I’m focusing on increasing the visibility of the initiatives that are already available to students. There are loads of training courses on this topic, for example, and not long ago there was a theatre performance on social security. Those are exactly the kinds of activities that I want to draw attention to.’
Ava has some more thoughts on improving the study experience for students: ‘It would be great if we could enable students to diversify their learning experiences, rather than focusing on studying nominally and providing standardised study pathways. We should let students explore other options instead, even outside our Faculty.’
As a prime example, besides mathematics, Ava has also completed a bachelor’s degree in Art History. ‘I really enjoyed looking for connections between my studies. Working in an interdisciplinary way brought me many new insights.’
But how do you create a strategic plan that encapsulates the views of everyone within the Faculty, including students? ‘I’m always looking for and speaking with all kinds of students,’ Ava says. ‘We brainstorm together about the strategic plan, for example, through consultation sessions on different topics, like digitalisation. In that case, it was very valuable to hear the opinions of students who are familiar with hybrid education. Eventually I hope the students feel they have contributed to the strategic plan as well.’
And that is what being the student assessor is all about, according to Ava: ‘The fact that I am speaking to so many passionate people makes it the best job ever. Everyone I meet is working so hard to make the University better. For a student to take a sneak peek inside the whole machinery that we call our Faculty is amazing.’
‘My job is challenging, but also a lot of fun’
Ava Bauer (22) is doing her bachelor’s in Mathematics at our Faculty on top of the Art History degree she has already completed. In the ’21 – ’22 academic year, she was president of the board at De Leidsche Flesch: the study association for Physics, Astronomy, Mathematics and Computer Science. This year she is the student assessor on the Faculty Board.


Chemistry master’s student Lucie Spek is the chair of the Faculty Council. Martina Huber, a lecturer in physics, is vice-chair, and together they communicate the expectations of faculty staff and students to the Faculty Board. ‘We listen to the students and staff, and the board listens to us.’
How does it feel to be chair and vice-chair of the council?
Lucie: ‘It feels good to make myself useful at the faculty! Last year I did a board year at the chemistry student association and got to know the faculty better. That’s how I became interested in being able to do things within the faculty, helping others and making positive changes.’
Martina: ‘I’ve been a member of the council for four years. Especially during corona, it became clear to me just how valuable this work is. The Faculty Board really listens to us and I realise how important it is to stay in close contact. So when I was asked to be the vice-chair, I didn’t hesitate.’
What does your job entail compared to the rest of the council?
Lucie: ‘We receive all the information from the faculty members and have to coordinate what happens with it. That could mean preparing a timetable or setting things in motion. It’s about making sure that the right subject gets discussed in the right place at the right time.’
Why did you want to become part of the council?
Lucie: ‘I want to represent students and get to know what is really going on internally. It’s good to have the council to discuss issues with and to reach a solution together that suits every institute and student.’
Martina: ‘And that works the other way around as well. It’s good for the Faculty Board to have feedback on how students and staff experience things.’
So you are the link between the board and the faculty?
Martina: ‘Exactly! We have to have the agreement of the board before certain changes can be made, so we also help to make decisions.’
Lucie: ‘And we want to make sure that things are not only put on paper, but are also put into practice.’
What is it like to work together as a student and associate professor?

Martina: ‘Our Faculty is the only one that has a student as chair and a staff member as vice-chair. It’s good to bring these two perspectives together’.
Lucie: ‘And Martina is someone who takes her own initiative herself and and makes sure it is followed through. It feels super nice to have her beside me.’
Martina: ‘I think Lucie is doing really well. It’s tough being in the council for the first time and especially being chair, so she’s incredibly brave to take on this position. I feel she is a very dedicated and passionate chair.’
Two very passionate people! Are you also ambitious in your free time?
Martina: ‘Sure, although my racing bike sadly gets neglected at the moment. But I always love the challenge of climbing a mountain.’
Lucie: ‘I play korfball in The Hague and I’m also in different committees there. I like organising and being involved in the things I care about.’

•
•

Our campus at Leiden Bio Science Park is changing rapidly. Over the coming years, the whole area will undergo a complete transformation. The result will be a sustainable and future-proof Leiden Science campus.

The campus will be a modern working environment with state-of-the-art teaching and research facilities. Outside it will be surrounded by many green spots where our staff, students and visitors can meet each other. The campus will be ready for use in 2024.

Why not imagine how it will be?
Imagine taking a walk around the campus. You arrive at our new campus and park your bike in a green bicycle shed. You might decide first to visit the rooftop garden - a pleasant green spot to relax. The Gorlaeus Building will open its doors, welcoming you to an area filled with space and light. Before lectures or a meeting, you can visit the café or meet with colleagues at the library. The renovated Lecture Hall building, too, will have a modern look and feel.
A large student housing complex will be constructed close to the brand-new campus square, which, by the way, will also be a great spot for meeting colleagues and friends. Curious about the new campus? Check out this plan and start looking forward to what the campus will have to offer: universiteitleiden.nl/en/gorlaeusbuilding
Iconic lecture hall is undergoing a complete metamorphosis

The main entrance of the Gorlaeus Building is based on a mathematical voronoi
The campus square will be a meeting place for everyone



This map is a current view of a part of the Leiden Bio Science Park. The map and schedule may be subject to change.

Hiring new staff, promoting employees and evaluating students. These are all areas where we can ask ourselves whether we treat all people equally. On International Women’s Day, #BreakTheBias flooded social media. Researchers in Science for Equality (RISE): ‘To break the bias, it is essential that everybody is aware of it. Only then can we be a truly diverse and inclusive university.’ Since 2015, RISE has been dedicating themselves to equal opportunities in science. We asked them: What do yóu do to break the bias?
RISE board member, associate professor at the Leiden Institute of Chemistry



‘We can only break the bias if we start at a very young age. So, I’m teaching primary school children about my research and work in chemistry. This lets them see that a scientist can also be a woman.’
Founder of RISE and board member, professor at the Leiden Academic Centre for Drug Research
‘Do you already know your unconscious biases? We use this question to make people aware of the biases they encounter at work. Let’s help each other to overcome these biases in hiring and promotions, in article citations, in student evaluations and more. Breaking the bias requires action from all of us!’
Founder of RISE and board member, Scientific Director and professor at the Institute of Environmental Sciences
‘Don’t think of yourself as the underdog, or in Dutch: Calimero. No more: ‘‘You’re big and I’m small, and that’s not fair’’. Instead, remember that everyone has their own struggles. Your internal struggles empower you and make you strong.’
“
RISE junior board, assistant professor at the Institute of Environmental Sciences
‘Breaking down biases is a process; it requires real investments of time, money and providing the space for discussions. Sometimes these discussions might be uncomfortable or seem less tangible than other ways to spend resources, but they are a top priority if we want to grow and develop our research.’
‘The first step towards breaking biases is to become aware of them, both the conscious and unconscious ones, because they are everywhere: we have biases regarding gender, people that look or don’t look like ourselves or people in authority. It’s important that we self-reflect and take action when we witness situations that involve some form of bias.’
RISE junior board, PhD candidate at the Leiden Observatory


‘Overcoming unconscious biases is as much an internal task as an organisational one. That means also looking critically at ourselves: how can we become more relaxed about discussing uncomfortable matters such as gender inequity, and organise constructive discussions on these issues?’
RISE junior board, assistant professor at the Institute of Advanced Computer Sciences

‘Biases often stem from a lack of information. Talking to a stranger, such as a colleague you’ve never spoken to before, can be a great way to learn more and break a bias that you didn’t even know you had. And it also works the other way around: they’ll learn about you as well! It helps you empower someone near you, such as a junior researcher or a neighbour’s kid, just by letting them know about yourself and what you do.’








There is no better way to show what goes on behind our Faculty's doors than to open them wide. The Leiden Science Family Day introduced more than 700 visitors to the Faculty of Science.




Young and old could enjoy fascinating experiments, guided tours, interesting lectures, spectacular nitrogen shows and lots of workshops. An inspirational day with the scientists of today and tomorrow and, above all, many happy faces.

STUDENTS
Nationalities
End 2022, among all students at our Faculty.
Nationalities
End 2022, among all students at our Faculty.
* End 2022, excluding guests
BSc & MSc students
Dutch 33 Non Dutch MSc students
STUDENTS FACULTY OF SCIENCE* Total 5898 83 % % 5 Non Dutch BSc students
% 57% 43 %
male female
STUDENTS FACULTY OF SCIENCE*
5898
BSc & MSc students
Dutch 33 Non Dutch MSc students
% 57% 43 %
* End 2022, excluding guests
male female
Leiden astronomers Melissa McClure, Harold Linnartz and Will Rocha are among the first scientists in the world to have access to Webb’s data. They will study the evolution of icy grains in space. It is on these icy grains that increasingly complex molecules, the building blocks of life, develop over time.



After 25 years, December 2021 finally saw the launch of the long-awaited James Webb Space Telescope. Leiden astronomers watched with great excitement. The whole year of 2022 was devoted to following Webb’s journey through to its final destination and awaiting the first results.
No need to be bored Galaxies in the early Universe, the origin of super massive black holes and hidden stars in the most highly star-forming galaxies: work enough to keep the Leiden astronomers very busy. Professor of Extragalactic Astronomy Mariska Kriek is aiming to unravel the genesis of galaxies: ‘I want to try and solve an astronomical mystery: why do some galaxies stop forming stars?’
In total, the Leiden Observatory gets 1400 hours of observation time with Webb, or 2000 hours including the time via the instrument teams. Eight Leiden principal investigators had successful open time proposals. Many researchers are also involved in other proposals

As early as 1997, Leiden astronomers were pressing to send along a hyper-sensitive infrared instrument. This became MIRI: the Mid Infrared Instrument that looks right through cosmic dust. Professor Bernhard Brandl guided the Dutch team that developed its spectrometer. ‘It can see light in the mid-infrared spectrum, at wavelengths invisible to the human eye.’ Professor Marijn Franx was involved with NIRSpec, which can measure the near-infrared spectra of multiple objects at once.

 Photo: Northrup Grumman
Photo: Northrup Grumman
Patients with skin diseases such as eczema and psoriasis sometimes spend a lifetime searching for the right treatment. To help these patients faster and better, scientists across the country are joining forces to develop personal treatment methods. ‘This is a collaboration using the expertise of so many different fields,’ Professor of Drug Delivery Technology Robert Rissmann says.
In the Netherlands, approximately 2.5 million patients suffer from chronic inflammatory skin diseases. ‘But patients nowadays receive a standard medicine that is often only partially effective or not effective at all,’ Rissmann says. ‘It can take years to search for the right medication that really works.’


With a grant for consortia of 11.7 million euros, 32 parties across the country have formed a consortium to provide patients with customised medicine. Medical university centres, patient associations, knowledge institutes and the pharmaceutical industry are all going to collaborate. ‘By combining the expertise of these different fields, we’re going to conduct very detailed measurements on patients and characterise them with new features.’ To find the right treatment for each patient, they first research the diseases thoroughly. ‘We use advanced technology to do that. For example, we can use skin biopsies to examine exactly which cells and molecules are involved.’
All the results of the clinical trials are registered in a central database. By sharing the data, everyone can use it for their field of research. ‘This project will enable a scientific breakthrough in understanding immuno-dermatological diseases. Together, we are going to work hard to put personal treatment into practice.’
Computers, tablets, mobile phones - just to name a few of the devices we use every day. Too bad the digital revolution of the last decades comes at a cost: consumer electronics make up a fast-growing share of our total waste. In 2022, Professor of Industrial Ecology Arnold Tukker received 3.8 million euros to help tackle this problem.


‘Producing all these devices involves a lot of materials,’ Tukker explains. ‘While that is already a problem on its own, it also means that there is a lot of waste when these devices are eventually discarded. Unfortunately, that waste is not processed efficiently enough, meaning many materials are lost as toxic waste, emissions or whatever.’
Where can we make the biggest difference?
Tukker will use the grant to analyse this problem from different perspectives: ‘Which parts of our devices contain what materials?
Where can we make the biggest difference? How can we redesign products in such a way that, after we have thrown them away, we can reuse more of their components?’
Working together with many partners
It is a complex puzzle that requires knowledge from fields as diverse as environmental systems analysis, manufacturing, design, and advanced waste sorting. ‘That’s why the work is done with a large number of knowledge partners such as TU Delft, TU Eindhoven, Erasmus University and some 20 national and international partners from the electronics industry,’ Tukker explains. ‘It is only by working together that we can radically change all aspects of electronics use.’
At the Leiden Institute of Environmental Sciences, scientists are quantifying the impact of changes in our diet on the climate. In Nature Food they write that by switching to a plant-based diet, highincome countries could draw almost 100 billion tons of CO2 from the atmosphere. In another study, scientists discovered that only a relatively small group of high-consuming Americans need to modify their diet to yield large reductions in climate impact.

Save the planet, change your diet
During the corona pandemic, scientists all over the world were trying to find an effective vaccine. To combine all these parallel studies, mathematician Judith ter Schure developed a new statistical method: ALL-IN meta-analysis. By combining the interim data, the method helps reach faster conclusions. ‘I hope our method will create a science environment where everyone is less concerned with their own paper and more with the big picture.’

Bacteria can temporarily live without a cell wall to hide from enemies such as viruses. PhD candidate Renée Kapteijn discovered that, while the cell wall is absent, bacteria can take up DNA and other tiny particles from their environment. ‘This represents a possible threat, because it could result in the bacteria acquiring new characteristics, such as better protection against antibiotics.’ The paper is a symbiosis between biology and chemistry, among the 50 Editor’s Highlights in the field this year.


Leiden chemists and their international colleagues have created a small sugar-like molecule with the potential for preventing metastasis in cancer. The molecule helps keep the tissue around a tumour firm and less penetrable. This way, any tumour cells that are dislodged have less chance to spread and colonise other sites in the body.


Physics is not the first scientific discipline that springs to mind at the mention of DNA. Nonetheless, biophysicist John van Noort uses it to study DNA structure in unprecedented detail. With the aid of a minuscule magnet, he and his colleagues discovered a new structure of telomeric DNA. Telomeres are seen as the key to living longer. They protect genes from damage but get a bit shorter each time a cell divides. The new discovery will help us understand ageing and disease better.

Can we live longer?
What’s on the outside does matter, Tobias Bauer from the Leiden Institute of Advanced Drug Research discovered. He found ways to improve drugs by encapsulating them Packages with iron nanoparticles, for example, can stimulate immune cells. ‘A capsule makes the drugs more soluble and selective,’ says Bauer. ‘The idea is that it should only open in the right situation, for example when the drug has reached the right location or cell type.’

How do you find relevant information in the incredible volume of archaeological reports stored in digital archives? Until now, archaeologists had to download every potentially relevant file and search them manually, report by report. With the help of his LIACS co-supervisor Suzan Verberne, archaeologist Alex Brandsen created a computer model that can take over that task: ‘It’s like Google... It can also recognise synonyms and look for information about a specific area.’

Quasars are supermassive black holes surrounded by a swirling disc of superheated gas. They are powerful particle accelerators that play an essential role in the formation and evolution of galaxies. However, quasars are hard to find because we see them as faint red dots, just like the much more numerous red dwarf stars. Using machine learning techniques, Leiden astronomers developed a new method to find distant quasars and better distinguish them from other objects.

Gerard van Westen (39) is Professor of Artificial Intelligence & Medicinal Chemistry at the Leiden Academic Centre for Drug Research, where he completed a master’s in Biopharmaceutical Sciences. During his PhD, he became intrigued by how machine learning could help with drug discovery. After a postdoc at the European Bioinformatics Institute in Cambridge, he returned to Leiden and completed a tenure track in close collaboration with LIC and LIACS.


If you needed to find the perfect match out of billions and billions of candidates for a job, you’d need a rock-solid selection process. The same applies if you want to find new medicines.
Professor of Artificial intelligence and Medicinal Chemistry Gerard van Westen uses algorithms to speed up this process and make it more efficient.
‘It takes an average of two billion euros and 12 to 15 years to find and develop a new drug,’ says Van Westen. ‘We want to use artificial intelligence, in short AI, to make that process more efficient.’ Especially at the beginning of the process, there is still a lot to gain, according to the professor. ‘AI helps us better select which of the thousands of drug candidates to move forward with to eventually create a new drug.’
By training the computer using data from previously published research, Van Westen and his colleagues created an AI model that can predict whether or not a candidate drug will work, or what it will do in the body. ‘There are around 2,000 approved drugs in the world but billions and billions of possibilities. You really need AI to sift through all those potential drug candidates.’
Deep-faking new drugs

And that’s not all. ‘The number of possibilities is too large for an exhaustive search. So, we also created a model that comes up with its own new ideas. It works a bit like a deep fake, where multiple images are combined to create a fake but realistic depiction of a person.
The models have seen all the medicines and all the candidates that are out there and, based on them, can make suggestions that a chemist can then work further with.’

Reduce animal testing, improve dosing ‘Making a virtual human is my end goal. We could then say: My AI suggested a drug candidate, and before I’ll test it on humans, I can already predict pretty well what it’s going to do. That will also help us reduce animal testing.’ Furthermore, Van Westen hopes such a virtual human will help to improve the dosing of drugs for populations that are not typically included in clinical trials, such as infants.
AI as an addition, not a replacement Van Westen is aware that there are two sides to the coin when using AI. ‘On the one hand, there are all the potential applications and new opportunities, but on the other, we shouldn’t put AI fully in the driving seat. Because we deploy our models very early in the process and it’s basically all virtual, the ethical element is barely present. AI is not a replacement, but a partner. However, it’s more than likely that scientists who use AI will replace the ones that don’t.’
‘With AI we are already at a stage where we can predict quite accurately whether a drug candidate is going to interact with more than one protein in the body. For example on-targets linked to function and off-targets linked to side effects. That’s awesome! Just imagine where we will be in ten, twenty years’ time.’
When you rent a scooter, you’re obliged to wear a helmet. But how clean is the headgear provided? A Dutch newspaper challenged our first-year biology students to find out. During a practical experiment, they determined the number of species of fungi and bacteria in nineteen different helmets. ‘One of the helmets was about as dirty as a dishcloth,’ says assistant professor Joost de Brink. ‘Fortunately, most of them proved to be clean.’

How gross is the helmet of a rental scooter?

A teacher who dresses up like the European flag on Brexit Day: if that's not dedication... Conservation biologist Emily Strange (left) won the Leiden Teaching Prize 2022. The judge praised her passion and her engaging personality, and the way she motivates her students. Strange teaches students from all different backgrounds: ‘By making the classroom interactive, all the students feel like they’ve got something to contribute and, hopefully, I avoid anyone thinking: I don’t know about this topic, so I’d better stay quiet.’

A place in the top 10 out of 360 teams, a gold medal and three special awards. The journey of iGEM Leiden 2022 came to a successful conclusion during the Grand Jamboree in Paris. At the iGEM contest, student teams from all over the world solve societal problems using synthetic biology.
‘We investigated how E. coli bacteria can produce metal nanoparticles that could improve photothermal therapy for people with head and neck cancer,’ says communications manager Windi Putri Wulandari.

Leiden student team successful in international contest

‘A Senior Teaching Qualification (SKO) doesn’t only recognise that you are excellent teachers with great skills and an inspiration to colleagues. You also have a clear vision and a leading role in educational innovation,’ said SKO chair Miranda van Eck. This year, no fewer than four certificates went to teachers from the Faculty of Science: Frank Takes, Stefano Cucurachi, Matthijs van Leeuwen and Marcel Schaaf (on the picture).

How are antibiotics a danger to mankind? And why is it unethical to completely ban the use of laboratory animals? At the Science Skills Lab, students from the Honours College studied scientific innovations and how they might affect our future. They pitched their end results in the Gorlaeus Building with life-size posters and visual props.
‘I appreciated collaborating with people from other studies,’ one of the students commented. ‘We learned a lot from each other’s interests and perspectives.’

For four months, 29 students gave weekly tutoring sessions to children at primary schools in neighbourhoods with a low socio-economic status. ‘During the Leiden Tutoring programme, they became real role models to the school children,’ says project manager Amber Bruijnzeel. ‘In turn, the students and staff learned to connect with a target audience outside their own social bubble.’ Besides tutoring, the programme also provided the Science & Society team with clues on whether interaction with students increases children’s interest in science subjects.


Research that lets you give the municipality a helping hand: both Nina Ruig (right) and Marron Loods are researching sustainability issues for the city of Leiden. The master’s students in Industrial Ecology took part in the Resilient Cities Hub, part of Learning with the City. Ruig is looking at what conditions make recycling

Missing legends, illogical connections or three-dimensional graphs. There are many ways in which data can deceive. Five maths students took up the struggle against misleading statistics with a free, online lesson series. ‘It’s mainly a training in media literacy,’ says one of the students. ‘How do you check whether information is reliable?
That means it fits in with all kinds of subjects, such as maths, social studies or economics.’

Mario van der Stelt (47) is professor of Molecular Physiology, and principle investigator at the Oncode Institute. In 2016, he founded the department of Molecular Physiology, which is embedded in the Chemical Biology division of the Leiden Institute of Chemistry. Van der Stelt aims to discover new molecules that can act as drug candidates for life-threatening diseases, such as Alzheimer’s, multiple sclerosis and cancer, for which there are as yet no suitable therapies available.

 Photo: Monique Shaw
Photo: Monique Shaw

How do you ensure that experimental cancer drugs make it to the finish? Over the next eight years, Oncode-PACT will receive 325 million euros from the National Growth Fund to find this out. Mario van der Stelt, professor of Molecular Physiology and principal investigator at the Oncode Institute, explains how.
‘Once an experimental drug is tested on humans, we actually don't yet know whether it's a good medicine,’ Van der Stelt explains. ‘Whether it is effective, for example, whether it is safe, whether it doesn’t break down in the liver. Because of this, patients are unnecessarily exposed to experimental drugs that don't work and may in some cases be toxic.’
Fortunately, nowadays there are many ways to know at an earlier stage whether an experimental drug has clinical potential. This could save an enormous amount of effort and money. Oncode-PACT wants to use these techniques to develop cancer drugs better and faster.
Anyone can apply ‘It is in oncology that the problem of inefficient drug development is greatest,’ Van der Stelt explains. ‘Only five percent of candidate drugs tested in humans succeed, whereas this number is 10 to 14 percent in other diseases. This has to do with the fact that cancer differs greatly from one individual to another and animal models are poor at predicting the disease.’
So, over the next eight years, Oncode-PACT will be building an infrastructure that brings together all the necessary knowledge and technology.
Anyone who wants to research a potential anti-cancer drug may come to them. ‘The process of developing a drug is so expensive and risky, hardly anyone can do it alone. Anyone can apply to our consortium, whether they are large academic groups or small biotech start-ups. Even if they are not affiliated with Oncode-PACT, if the research is promising, we will provide the resources and the infrastructure.’
New medicines faster
Those resources include not only money, but also the latest academic insights and technologies that make drug research more efficient, using artificial intelligence, for example. Gerard van Westen, professor of AI and Medicinal Chemistry at the LACDR, is working on developing a virtual human for this purpose. It consists of algorithms that predict what an administered substance does in our bodies.
Another technique that is revolutionising drug discovery research, but is not yet accessible to everyone, is cryo-electron microscopy. ‘This technique makes visible in close detail the structure of proteins that drugs act on and how that happens. This knowledge guides the design of new drugs. Oncode-PACT is investing in the Netherlands Centre for Electron Nanoscopy (NeCEN) to make this technology available to its network.’
A well-oiled machine
So, what is the first thing Van der Stelt will do as one of the leaders of Oncode-PACT? ‘Building a solid organisation with all the stakeholders, so that we can select the best projects that get access to the complete network of knowledge, expertise and infrastructure within Oncode-PACT. This will gradually create a well-oiled machine that brings new cancer medicines much closer, faster and more efficiently.’









A market stand with liquid nitrogen experiments, a draw-a-scientist contest, a quantum block party, and a daily radio programme full of fun science facts. In 2022 Leiden was the European City of Science. That meant 365 days filled with fascinating, inspiring and fun activities that sparked curiosity in everyone who took part.
How do you engage the general public in science? By going into the neighbourhood and bringing it to them. And that’s what the researchers from our Faculty did: connecting with people on the street in lots of different ways.
In a local neighbourhood, scientists gave short lectures on quantum, for example. ‘I want to become a scientist when I grow up,’ one young boy said, ‘so I’m here to learn about it already.’ All these events resulted in some insightful interactions – not only for the audience, but for the scientists as well.



Children are perfect scientists: always bursting with curiosity and exploring how the world works. Yet many of them barely get a chance to be engaged in science. Leiden scientists therefore co-founded Lil’Scientist: a project that gives children a chance to participate in real scientific research. ‘We’ll put the children in charge,’ says co-founder and astronomer Frans Snik. ‘I can’t wait to see the results of their enthusiasm and boundless thinking.’

It is around a third of the thickness of a human hair and invisible to the naked eye: the 3D-printed statue of Rembrandt made by artist Jeroen Spijker and physicists Daniele Kraft and Rachel Doherty. You can see the sculpture in Museum De Lakenhal in Leiden, but only with a microscope. ‘The Rembrandt project is helping us discover the limits of our devices,’ says Doherty. ‘How small can we go?’

Forget Python, Java and Scratch: there is now an accessible programming language for children. This is Hedy, invented by computer scientist Felienne Hermans from LIACS. Thanks to a collaboration between Jetlearn, an online programming school based in Amsterdam, and Leiden University, Hedy now has translations in Hindi and Bengali. In addition, the language is now also available in Arabic. This means that millions of children can now learn how to programme!

Street lamps switched off and buses went around the block: anything to get the centre of Leiden as dark as possible. During Seeing Stars Leiden in the evening of 25 September, the city kept light pollution to a minimum. People gathered across the darkened city centre to marvel at all the twinkling beauty that normally remains hidden. Despite the cloudiness, many stars - and even planets, such as Jupiterappeared bright in the Leiden sky.

Strengthening nature and at the same time investing in future-proof agriculture. That’s the task of the Dutch Minister for Nature and Nitrogen, Christianne van der Wal. It is also the lifework of Leiden professor Jan Willem Erisman. This nitrogen expert has shown that nature and agriculture do go hand in hand. On 9 June, he presented the Minister with his book The dairy cattle revolution. Lessons from the agricultural transition on Schiermonnikoog.

Amorphophallus titanium: everything sounds fancier in Latin, but there’s no getting around the fact that this flower is called the giant penis plant. This year, the specimen at the Hortus botanicus flowered for the first time since 2009: a must-see for flora fans. The penis plant is infamous for its immense inflorescence, which can reach three metres in height, and for its pungent scent. Despite the smell, many people dared to pay a visit.

Children love animals, and picture books are full of them. However, not all animals are featured equally. The majority are mammals, biologist Michiel Hooykaas discovered. ‘Domesticated and exotic animals are particularly popular,’ he says. ‘But there are plenty of opportunities to give other Dutch fauna their moment of fame. If kids are more connected to the creatures around them, they will be more prone to protect them.’
 Photo: Taco van der Eb
Photo: Taco van der Eb
The Dutch Minster of Education, Culture and Science, Robbert Dijkgraaf, has appointed Professor Ionica Smeets and Alex Verkade (Taskforce for Applied Research SIA) as coordinators of a new national centre for science communication. The goal: not more but better science communication. Smeets: ‘Science communication occurs in many places and in many forms – and so many people have to reinvent the wheel every time. There’s a lot to be gained by sharing expertise.’

 Photo: Simone van ’t Zelfde
Ionica Smeets: National coordinator science communication
Photo: Simone van ’t Zelfde
Ionica Smeets: National coordinator science communication
universiteitleiden.nl/science universiteitleiden.nl/science-talents-and-discoveries